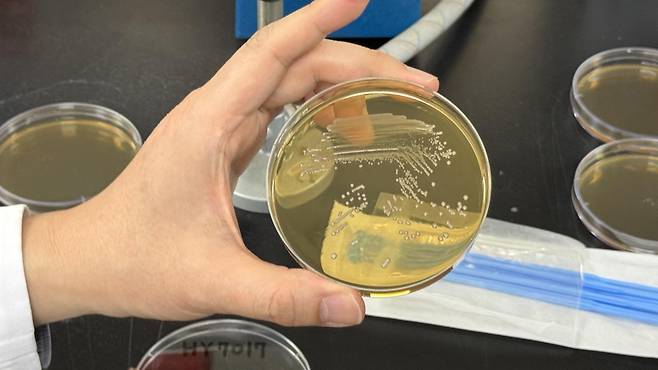
인큐베이터 배양 과정을 거쳐 균주가 점 형태의 집락을 형성했다. 김혜린 기자 sinnala8@donga.com

“K-유산균 글로벌 영토 넓힐 전초기지”… 50년 역사 hy 중앙연구소 가보니
국내 유일 ‘대장 모사 시스템’ 보유… 마이크로바이옴 연구 집중

양준호 hy 연구기획팀장은 23일 경기 용인시 기흥구에 위치한 hy 중앙연구소에서 연구소의 비전에 대해 이같이 말했다. 1976년 출범한 연구소가 언론에 공개된 것은 이번이 처음이다.
이곳은 균주 발굴부터 기능성 개발, 시제품 제작까지 전 과정을 수행하는 hy의 핵심 기지다. 양 팀장은 “국내 기업 중 균주 발굴부터 산업화·유통까지 전 과정을 수행하는 기업은 거의 없다”며 “원료뿐만 아니라 완제품까지 자사 공장에서 생산하고 프레시 매니저를 통해 공급하는 역할도 하고 있다”고 자부했다.



이렇게 확보한 균주를 대상으로 내산성·장 정착성·안전성 등을 평가한다. 검증을 통과한 균주에는 사람의 주민등록번호 격인 ‘스트레인 넘버(strain number)’를 부여해 관리하고 있다.
핵심 자산인 균주 라이브러리도 볼 수 있었다. 영하 80도 초저온 냉동고에는 5000여종이 넘는 균주가 보관돼 있다. hy는 화재 등 비상 상황에 대비해 동일한 균주 세트를 세 곳에 분산 보관하고 있다.

염증 수치가 높을수록 짙은 색을 띠는데 시약을 투여하자 염증이 유발된 세포군은 짙은 보라색으로 변했다. 반면 프로바이오틱스를 처리한 세포는 항염증 약물을 투여한 대조군만큼이나 색이 옅게 나타났다. 해당 균주가 염증 완화 효과를 보였다는 의미다.


기자가 추출된 배양액을 맛보니 무가당 그릭요거트와 같이 시큼했다. 이 배양액에 시럽과 향을 배합하면 시판 요구르트와 같은 맛이 난다. 이응석 유제품팀장은 “프로바이오틱스라는 주연 배우가 시럽, 향료 등 조연들과 어우러져 제품이라는 영화가 탄생하는 과정”이라고 설명했다.
hy의 균주를 과학적으로 증명하는 것은 신성장팀의 몫이다. 신성장팀은 식품의약품안전처로부터 균주의 기능성을 개별로 인정받고 소재를 산업화하는 역할을 한다. 최일동 신성장팀장은 “최근 소비자들은 장 건강을 넘어 피부, 다이어트, 면역 등 다양한 기능성을 요구한다”며 “과학적 근거를 확보해 제도권에서 공식 인정받는 것이 우리의 역할”이라고 말했다.
최 팀장은 “프로바이오틱스를 먹더라도 성별, 인종, 나이, 질병 상태, 식습관, 생활 패턴 등에 따라 효과에는 차이가 있다”며 “프로바이오틱스의 다양한 기능성을 밝히기 위해 마이크로바이옴을 이해하는 것은 미지의 세계로 나가는 데 큰 도움이 된다”고 말했다.
hy는 국내를 넘어 글로벌 시장에서 프로바이오틱스 대표 기업으로 인정받는 것을 목표로 삼고 있다. 양준호 팀장은 “국내에서는 hy가 프로바이오틱스 대표 기업으로 통하지만 해외 인지도는 아직 높은 편이 아니다”라며 “수년 전부터 글로벌 스탠다드에 부합하는 양적·질적 데이터를 확보하기 위해 노력하고 있다”고 밝혔다.
실제로 hy는 매년 논문 및 특허 개발에 힘을 쏟고 있다. 현재 124건의 특허를 등록했으며, 매년 10~15건의 논문을 발표하고 있다. 해당 논문들은 글로벌 표준인 국제 학술지(저널)에도 꾸준히 게재되고 있다는 게 연구소 측의 설명이다.
양 팀장은 “지난 50년이 국내 1등 프로바이오틱스 기업으로 인정받는 과정이었다면 향후에는 ‘글로벌 넘버 원’이 되는 것이 연구소의 미션”이라며 “hy를 외부에 소개했을 때 충분히 인정받을 수 있는 수준이라고 자신한다”고 덧붙였다.
김혜린 기자 sinnala8@donga.com
Copyright © 동아일보. All rights reserved. 무단 전재, 재배포 및 AI학습 이용 금지
- 美·이란 ‘총성 없는 소모전’ 가나…트럼프 “협상 서두르지 않겠다”
- 장동혁, 사퇴 요구 일축…“선거 마무리하고 평가받겠다”
- 강훈식 “5월 원유 도입량, 작년의 87%…중동 의존도 13%P 낮춰”
- 李 “터무니없는”-정동영 “저의 의심”…위성락은 “사달났다”
- 작전 미리 안 美특수부대원 ‘마두로 실각’ 베팅해 6억 벌어
- 태진아 공연장 나타난 유승준 “아직도 한국 못가?” 응원에 울컥
- ‘가짜 늑구’ 사진 유포한 40대 회사원 검거…“재미로 그랬다”
- 靑 “대통령, 장기특공 비거주·거주 구분 강조…정부 논의 중”
- 한동훈 부산북갑 출마 “좋지 않게 본다” 49%
- 14억 내면 美영주권 발급…논란의 ‘트럼프 골드카드’ 승인자 단 1명